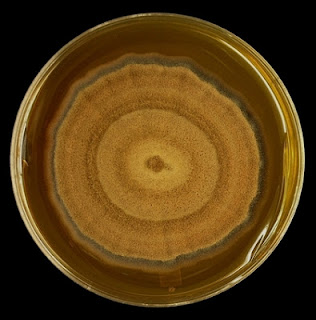

Pleruostomophora richardsiae
Note: Recent taxonomic changes have placed the fungus formerly known as Phialophora richardsiae into a different genus - now known as Pleruostomophora richardsiae.
Ecology: Pleruostomophora richardsiae is widely distributed and may be isolated from decaying wood and wood pulp items as an agent of ‘soft rot’.
Macroscopic Morphology: P.richardsiaeexhibits moderate growth and will mature in about 6 to 10 days depending on temperature. Growth is inhibited at 35oC and above. Colonies are olive brown to a grey brown in colour. Texture has been described as velvety to woolly and even powdery. The reverse is dark brown in colour.
Pleruostomophora richardsiae - SAB media at about 3 weeks incubation at30oC.
Note: colour of colony appears lighter in this photograph than in actuality. For safety, all fungal plates presented in this were photographed within a biological safety cabinet (laminar flow hood) where lighting conditions are difficult to control. Photo-editing programs could not adequately restore the actual colour. (Nikon)Microscopic Morphology: P.richardsiaeproduces septate hyphae which are hyaline (clear) which develop a brown colour as they mature. One of the most recent mycology texts[i]states that Pleruostomophora richardsiaeproduces phialides that usually, but not always, have a distinct septum at the base and are slightly flask-shaped with a characteristic flared, saucer-shaped collarette.
Several earlier sources[ii]state that Phialophora richardsiaeproduces two types of phialides: 1)with short, inconspicuous adelophialides (lacking a basal septum) which produce hyaline, single-celled conidia, which are cylindrical to occasionally allantoid (sausage shaped), (3–6 µm X 2-3 µm); 2) dark brown, slender, sometimes septate phialides with prominent, dark, flaring collarettes producing hyaline (initially) to brown, thick-walled globose to subglobose conidia (2.5 –3.5 µm X 2–3 µm). Another source describes this second type of phialide as a simple, short, unflared phialide which may form along the hyphae and produce conidia that are hyaline and cylindrical or slightly curved. While this may be one subtle distinguishing feature between the old and new genera, I didn’t follow up on this discrepancy with further inquiry.
P.richardsiae- Graphic illustrating a phialide with septa at base (1a), one without 1(b) and what some sources describe as a simple, undifferentiated phialide. These undifferentiated phialides were not seen noted in the isolate shown below.
P.richardsiae - First look at a slide culture (~72hrs) at low magnification.
(LPCB, 400X, DMD-108)
P.richardsiae - at high magnification darkening septate hyphae are seen with a couple of flask-shaped phialides visible in this photo. Numerous single celled elongated conidia are produced and stain intensely with the lacotophenol cotton blue (LPCB) stain.
(LPCB, 1000X, DMD-108)
P.richardsiae - Another view. A flask shaped phialide is seen in the center of the photograph with several elongated, sausage shaped conidia, at the apex. Micron bar appears at the top of the photograph for scale.
(LPCB, 1000X, DMD-108)
P.richardsiae - A number of young phialides extending from the hyphae are seen at the left of the photograph. A single brown coloured phialide is seen near the upper middle of the photograph. The collerette is visible at the phaialides apex.
(LPCB, 1000X, DMD-108)
P.richardsiae - Another view. Several flask-shaped phialides are seen extending from the septate hyphae. As they extend in many directions from the hyphae, some will always be out of the focal plane of the camera and therefore appear out of focus.
(LPCB, 1000X, DMD-108)
P.richardsiae - Phialide (arrow) with conidia at the apex.
(LPCB, 1000X, DMD-108)
P.richardsiae- Two phialides are seen in the center of the photo (thin arrows) with distinct septa visible at their base (thick arrows).
(LPCB, 1000X, Nikon)
P.richardsiae- Another phialide with septa at base and barely visible, delicate collerette at apex. (LPCB, 1000X, Nikon)
P.richardsiae- Single phialide tapering towards apex where a delicate, saucer-shaped collerette is visible. Conidia are seen at the apex. Structure appears larger than in other photos of same magnification due to cropping of photograph.
(LPCB, 1000X, Nikon)
P.richardsiae - another view of the same.
(LPCB, 1000X, Nikon)
P.richardsiae- Another photo of the same structures. Phialides extending from hyphae on left side of photo are protruding upwards and out of the focal plane of the camera. Phialide in center is shown enlarged (inset) where the delicate, saucer-shaped collerette is visible and a single conidium protrudes at the tip. Micron bar at top of photo for scale.
(LPCB, 1000X, DMD-108)
P.richardsiae- More is better! A couple more photographs Here is a phialide with its saucer-shaped collertte. (LPCB, 1000X, DMD-108)
P.richardsiae - Septate brown hyphae with phialide and conidia.
(LPCB. 1000+10X, DMD-108)
P.richardsiae - And yet another photo which better shows the delicate, saucer-shaped colleretteand conidia still gathered at apex.
(LPCB. 1000+10X, DMD-108)
P.richardsiae - Septate hyphae with long, tapering phialide. Collerette visible at the tip no longer appears saucer-shaped, extending laterally, but is more vertical.
(LPCB. 1000+10X, DMD-108)
P.richardsiae - and another of same. Collerette (arrow)
(LPCB, 1000X, DMD-108)
P.richardsiae - (LPCB, 1000X, Nikon)
The isolate presented in this post tends to agree with the first & most recent description in having somewhat flask-shaped phialides with and without basal septa. Phialides all appear to have a somewhat saucer-shaped delicate collarette although some appear to have closed up (more vertically than flaring laterally) once the conidia have dispersed.
To compare Pleurostomaphora (Phialophora) richardsiae to Phialophora verrucosa please visit my previous post Here.
Pathogenicity: Though uncommon, P.richardsiae is known to be an agent of subcutaneous phaeohyphomycosis. Infection usually occurs after implantation of the fungus by traumatic injury. Collagenous cysts may encapsulate the fungus at the site of entry. Infection may be more common in immunocompromised patients and those with diabetes mellitus.
Pleurostomophora richardsiae - Computer wallpaper (1024 X 768 when Posted)
[i]Medically Important Fungi, 5th Edition–A Guide to Identification; Davise H. Larone MT (ASCP), PhD. F(AAM)
ASM Press, Washington DC
[ii]Guide to Clinically Significant Fungi, Deanna A Sutton, B.S., MT, SM (ASCP), RM, SM (AAM), Annette W. Fothergill, M.A., M.B.A., MT (ASCP), CLS (NCA), Michael G. Rinaldi, PH.D; Publisher: Lippincott Williams & Wilkins; 1 edition, Baltimore, MD, USA (1997)

.jpg)